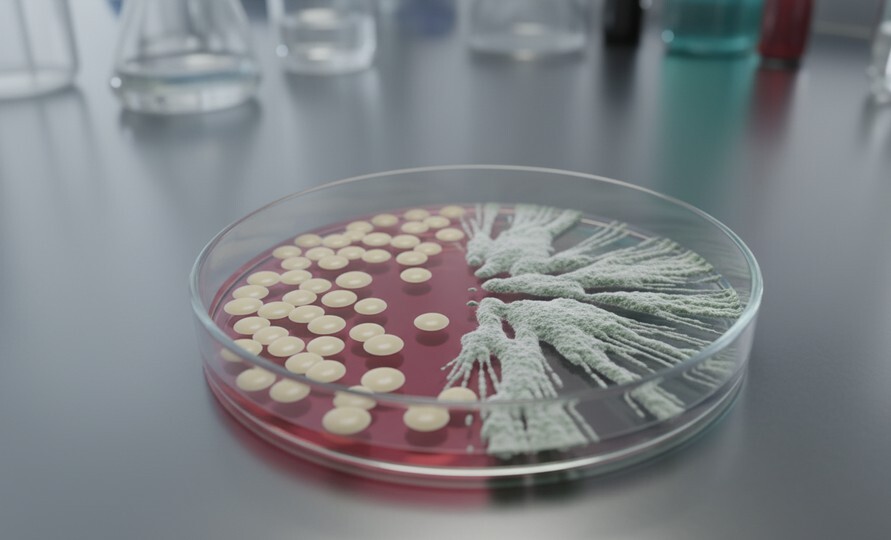
Причина белых творожистых выделений - грибок Candida

⚡️ 9 из 10 человек едят ШАШЛЫК, опасный для здоровья. А вы?
Мы используем файлы cookie для улучшения вашего пользовательского опыта. Продолжая, вы соглашаетесь с нашей Политикой Конфиденциальности.
Белые густые выделения у женщин: норма, причины патологий и что делать
Опубликовано
Автор:
Солошина Наталья Сергеевна
Обновлено
На чтение
Просмотров
Об авторе
с 2015 года.
--
--
--
0

Белые густые выделения (бели) — это чаще всего вариант нормы, связанный с работой женской репродуктивной системы. Но изменение их цвета, запаха или консистенции, а также сопутствующий дискомфорт могут сигнализировать о заболевании. Эта статья поможет вам отличить норму от патологии и подскажет, когда нужно обратиться к врачу.
Статья проверена и обновлена врачом акушером-гинекологом Натальей Сергеевной, опыт работы с 2015 года.
Как отличить норму от патологии: гид по самодиагностике
Используйте эту таблицу для быстрой оценки вашего состояния. Если ваши симптомы совпадают с колонкой «Возможная патология», незамедлительно проконсультируйтесь с врачом-гинекологом. Сегодня это можно сделать быстро и конфиденциально, например, с помощью сервиса «Медведь.Телемед».

Почему появляются белые выделения: физиологические причины
Физиологические бели — это не грязь, а естественная секреция, которая выполняет важнейшие функции: увлажняет слизистую оболочку, поддерживает здоровую микрофлору и защищает от инфекций. Давайте разберемся, какими они бывают в норме.
Базовые характеристики нормальных выделений
В норме вагинальная секреция состоит из слизи, вырабатываемой железами шейки матки, и слущенных клеток эпителия. За кисловатый запах и кислую среду отвечают лактобактерии — наши главные защитники. Нормальные выделения могут быть от жидких и водянистых до кремообразных и густых, объемом до одной чайной ложки в день. Их цвет варьируется от прозрачного и белесого до молочного или кремового. При высыхании на белье они могут оставлять слегка желтоватый след, и это тоже вариант нормы.
Как выделения меняются в течение жизни и цикла
Характер выделений напрямую зависит от гормонального фона, который меняется не только в течение месяца, но и на протяжении всей жизни женщины.
В разные фазы менструального цикла
После менструации обычно наступают так называемые «сухие дни», когда секреция практически отсутствует. Ближе к середине цикла, перед овуляцией и во время нее, под действием эстрогенов выделения становятся обильными, прозрачными и тягучими, по консистенции напоминая яичный белок — так организм создает благоприятную среду для сперматозоидов. После овуляции наступает вторая фаза цикла, где правит гормон прогестерон. В это время выделения становятся густыми, кремообразными, белого или желтоватого цвета, а их количество уменьшается. Такие густые выделения перед месячными абсолютно нормальны.
В особых ситуациях
Во время беременности, особенно в первом триместре, из-за мощной гормональной перестройки выделения часто становятся более обильными, густыми и молочно-белыми. При сексуальном возбуждении железы преддверия влагалища производят обильную прозрачную смазку — это отдельный тип секреции. А на фоне приема гормональных контрацептивов (ОК) выделения, наоборот, могут стать более скудными и вязкими.
Какие симптомы должны насторожить: признаки патологии
Следующие изменения — это «красные флаги», которые нельзя игнорировать. Они требуют обязательной консультации гинеколога для своевременной диагностики и лечения.
«Моя хорошая, запомни простое правило: любые выделения, сопровождающиеся зудом, жжением, неприятным запахом или болью — это абсолютный повод для визита к врачу. Самолечение может 'смазать' клиническую картину, усложнить диагностику и привести к хроническому течению болезни, с которым бороться гораздо сложнее», — комментирует врач акушер-гинеколог Наталья Сергеевна.
Изменение консистенции и цвета
Творожистые, комковатые белые выделения или белые крупинки — это классический признак молочницы (кандидоза). Если выделения стали серовато-белыми, однородными и пенистыми, это может указывать на бактериальный вагиноз или трихомониаз. Желтый или зеленоватый оттенок почти всегда говорит о наличии гнойного воспалительного процесса, который часто вызывают инфекции, передающиеся половым путем (ИППП), или неспецифический вагинит.
Появление неприятного запаха
Резкий «рыбный» запах, который усиливается после полового акта или во время менструации, характерен для бактериального вагиноза. Кислый запах, более резкий, чем обычно, может усиливаться при кандидозе. Появление гнилостного запаха — крайне тревожный симптом, который может сигнализировать о серьезном воспалении или наличии инородного тела.
Сопутствующий дискомфорт
Зуд, жжение, раздражение и отек наружных половых органов являются частыми спутниками инфекций. Боль и дискомфорт при мочеиспускании (дизурия) или во время полового акта (диспареуния) также сигнализируют о проблеме. Если к измененным выделениям присоединяются тянущие боли внизу живота, это может говорить о распространении воспалительного процесса на органы малого таза.
Основные причины патологических выделений (Заболевания)
Аномальные белые (и не только) выделения почти всегда являются симптомом конкретного заболевания. Вот наиболее частые из них.
Вагинальный кандидоз (молочница)
Классические симптомы этого грибкового заболевания — густые, белые, творожистые выделения, похожие на крупинки творога, и сильный, изнуряющий зуд. Причинами и факторами риска служат снижение иммунитета, прием антибиотиков, стресс, погрешности в диете с избытком сладкого и даже ношение тесного синтетического белья.
Бактериальный вагиноз (БВ)
Это не инфекция в чистом виде, а дисбаланс микрофлоры, когда количество полезных лактобактерий снижается, а их место занимают условно-патогенные анаэробные микроорганизмы. Симптомы включают умеренные, однородные, серовато-белые выделения с характерным «рыбным» запахом. Зуд и жжение выражены слабо или отсутствуют.
Инфекции, передающиеся половым путем (ИППП)
Трихомониаз
Это заболевание проявляется желтоватыми или зеленоватыми, пенистыми выделениями с неприятным запахом, часто сопровождается зудом и жжением.
Хламидиоз и гонорея
Эти инфекции коварны тем, что часто протекают со скудными симптомами или вовсе без них. Иногда они могут вызывать желтоватые гнойные выделения из шейки матки, которые женщина замечает как изменение характера своей обычной секреции.
Воспалительные заболевания органов малого таза (ВЗОМТ)
Это серьезное состояние, когда инфекция поднимается выше во влагалище, поражая матку, маточные трубы или яичники. Оно может сопровождаться обильными гнойными выделениями, болями внизу живота и повышением температуры.
Какие анализы и обследования назначает гинеколог для диагностики?
Установить точный диагноз и назначить правильное лечение может только врач. Попытки самостоятельной диагностики по фото из интернета или советам подруг часто ведут к ошибкам и хронизации процесса.
Что происходит на приеме у гинеколога
На приеме, будь то очная встреча в клинике или онлайн-консультация, я в первую очередь подробно расспрошу вас о жалобах, истории их появления и образе жизни. Затем следует осмотр на гинекологическом кресле, во время которого я оцениваю состояние слизистых и беру мазки для анализа. Весь процесс проходит в атмосфере доверия. Безопасность ваших данных, как медицинских, так и персональных, является нашим приоритетом, что роднит подход «Медведь.Телемед» с надежностью швейцарского банка.
Ключевые анализы для постановки диагноза
Для определения причины назначаются специальные исследования. Базовый анализ — это микроскопия мазка на флору, который показывает общее состояние микрофлоры, наличие воспаления и грибов. «Золотым стандартом» для выявления ИППП и детальной оценки баланса микроорганизмов служат ПЦР-тесты, такие как Фемофлор или Флороценоз. При частых рецидивах может потребоваться бакпосев выделений, который определяет конкретного возбудителя и его чувствительность к антибиотикам.
Методы лечения и восстановления микрофлоры
Важно! Схема лечения подбирается врачом строго индивидуально на основе результатов анализов. Самолечение недопустимо и может быть опасно для вашего здоровья!
Лечение основной причины
В зависимости от диагноза терапия будет разной. Кандидоз лечится противогрибковыми препаратами в виде свечей, кремов или таблеток. При бактериальном вагинозе назначается антибактериальная терапия, например, препараты метронидазола или клиндамицина. Лечение ИППП требует специфических антибиотиков, и в этом случае обязательной терапии подлежат оба половых партнера.
Восстановление нормальной микрофлоры
После завершения основного курса лечения крайне важно восстановить здоровый баланс микрофлоры. Для этого я назначаю пробиотики с лактобактериями, которые выпускаются в форме вагинальных свечей или капсул для приема внутрь. Это помогает нормализовать pH, заселить влагалище "хорошими" бактериями и предотвратить повторение проблемы.
Профилактика: как поддерживать здоровье и избежать проблем
Профилактика всегда лучше лечения. Соблюдая простые правила, вы можете значительно снизить риск развития патологических состояний.

Ключевые правила интимной гигиены
Подмывайтесь простой водой или специальным мягким средством с нейтральным pH не чаще двух раз в день. Откажитесь от спринцеваний — они вымывают полезную микрофлору. Носите белье из натуральных дышащих тканей, например, хлопка.
Роль безопасного секса и барьерной контрацепции
Использование презервативов является надежным методом защиты не только от нежелательной беременности, но и от большинства инфекций, передающихся половым путем.
Влияние питания (ограничение сахара) и образа жизни
Сбалансированное питание с ограничением простых углеводов (сахар, выпечка) помогает сдерживать рост грибков Candida. Достаточный сон, управление стрессом и умеренная физическая активность укрепляют иммунитет, который стоит на страже здоровья всего организма, включая интимную сферу.
Важность регулярных осмотров у гинеколога (1 раз в год)
Профилактический визит к гинекологу один раз в год — это ваша лучшая инвестиция в здоровье. Он позволяет выявить возможные проблемы на самой ранней стадии. Современные сервисы, такие как «Медведь.Телемед», позволяют легко записаться на прием или получить консультацию, не откладывая заботу о себе на потом.
Часто задаваемые вопросы
Могут ли белые густые выделения быть единственным симптомом заболевания?
Да, такое возможно. Например, при некоторых формах хламидиоза или на начальных стадиях других инфекций может не быть ни зуда, ни запаха. Поэтому любой нетипичный характер выделений, который вас настораживает, — это уже достаточный повод для проверки у врача.
Что делать, если аномальные выделения появились во время беременности?
Немедленно сообщить своему акушеру-гинекологу, который ведет вашу беременность. Не занимайтесь самолечением! Многие состояния, например, бактериальный вагиноз или молочница, требуют обязательного лечения во время беременности, чтобы не навредить здоровью будущего малыша.
Нужно ли лечить полового партнера?
При выявлении ИППП (хламидиоз, трихомониаз, гонорея и др.) лечение полового партнера является обязательным, иначе произойдет повторное заражение. При рецидивирующем кандидозе или бактериальном вагинозе вопрос о лечении партнера я решаю индивидуально в каждом конкретном случае.
Почему молочница или баквагиноз постоянно возвращаются?
Причины рецидивов могут быть разными: не до конца вылеченная первичная инфекция, наличие скрытых факторов риска (например, недиагностированный сахарный диабет, иммунодефицит), неправильно подобранная терапия или повторное инфицирование. Такая ситуация требует углубленной диагностики для поиска первопричины.
Могут ли ежедневные прокладки провоцировать проблему?
Да, особенно ароматизированные. Они создают «парниковый эффект», нарушают доступ кислорода к коже и слизистым, а химические отдушки могут вызывать раздражение. Все это создает благоприятные условия для роста патогенной флоры. Лучше использовать их только в дни предполагаемого увеличения выделений, а не на постоянной основе.
Поделиться:
Задать вопрос гинекологу онлайн
Готовы решить вопрос сегодня?
Оставьте контактные данные, и оператор свяжется в течение 5 минут в Telegram/ What'sApp
Оставьте контактные данные, и оператор свяжется в течение 5 минут в Telegram/ What'sApp
Читайте также:
Проверь себя
Болит, а врачи разводят руками?
Возможно, причина в эмоциях
Бесплатный чек-лист
по симптомам психосоматики в гастроэнтерологии:
по симптомам психосоматики в гастроэнтерологии:
- Боли в животе.
- Изжога.
- Тошнота, рвота и отрыжка.
Нажимая на кнопку, вы соглашаетесь
с Политикой конфиденциальности, Согласием на обработку персональных данных.
с Политикой конфиденциальности, Согласием на обработку персональных данных.

